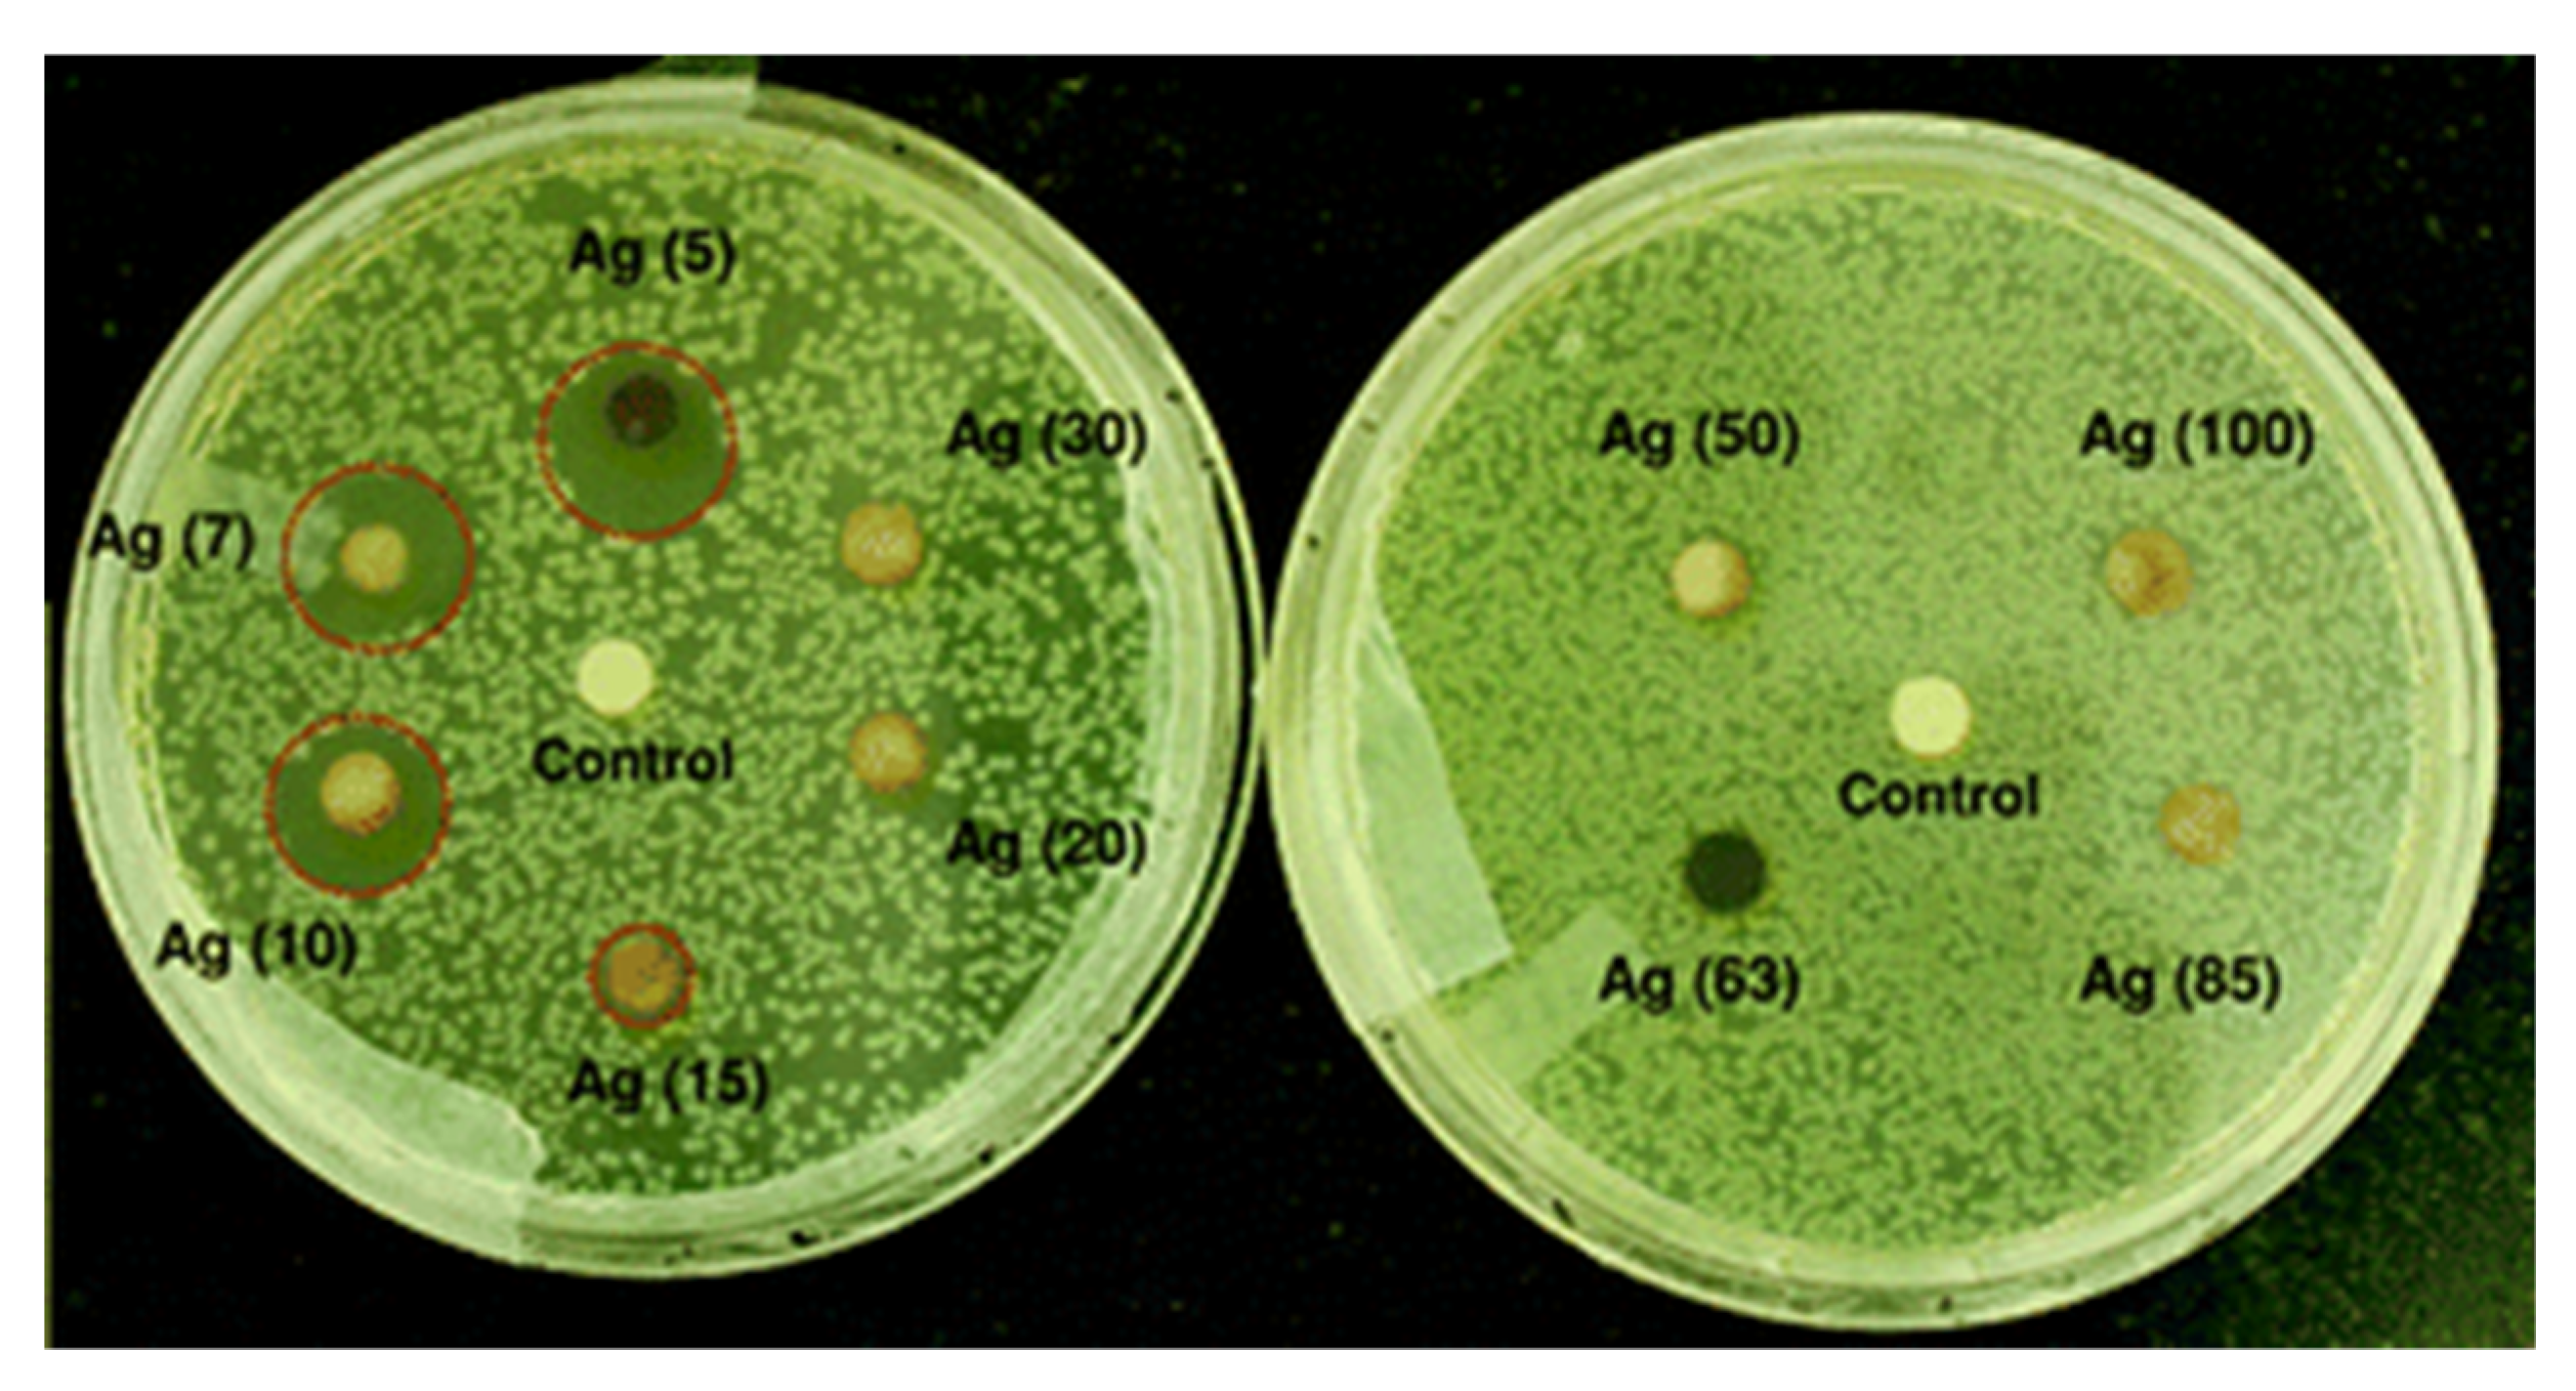

Bactericidal and Cytotoxic Properties of Silver Nanoparticles
Abstract
1. Introduction
2. Synthesis of AgNPs and Their Polymer Nanocomposites
2.1. Wet Chemical Route
2.2. Biological Route
2.3. AgNP-Polymer Nanocomposites
3. Antibacterial Activity
3.1. Biosynthesized AgNPs
3.2. Polymer-AgNPs Nanocomposites
3.2.1. Nanocomposite Fabrics
3.2.2. Food Packaging Nanocomposite Films
3.2.3. Nanocomposite Wound Dressings
4. In Vitro Cell Cultivation
5. In Vivo Animal Model
6. Conclusions
Author Contributions
Funding
Conflicts of Interest
References
- Tjong, S.C.; Chen, H. Nanocrystalline materials and coatings. Mater. Sci. Eng. R Rep. 2004, 45, 1–88. [Google Scholar] [CrossRef]
- He, L.X.; Tjong, S.C. Aqueous graphene oxide-dispersed carbon nanotubes as inks for the scalable production of all-carbon transparent conductive films. J. Mater. Chem. C 2016, 4, 7043–7051. [Google Scholar] [CrossRef]
- He, L.X.; Tjong, S.C. Nanostructured transparent conductive films: Fabrication, characterization and applications. Mater. Sci. Eng. R Rep. 2016, 109, 1–101. [Google Scholar] [CrossRef]
- He, L.; Liao, C.; Tjong, S.C. Scalable fabrication of high-performance transparent conductors using graphene oxide-stabilized single-walled carbon nanotube inks. Nanomaterials 2018, 8, 224. [Google Scholar] [CrossRef] [PubMed]
- Liu, C.; Shen, J.; Yeung, K.W.K.; Tjong, S.C. Development and antibacterial performance of novel polylactic acid-graphene oxide-silver nanoparticle hybrid nanocomposite mats prepared by electrospinning. ACS Biomater. Sci. Eng. 2017, 3, 471–486. [Google Scholar] [CrossRef]
- Liu, C.; Chan, K.W.; Shen, J.; Wong, K.M.; Yeung, K.W.; Tjong, S.C. Melt-compounded polylactic acid composite hybrids with hydroxyapatite nanorods and silver nanoparticles: Biodegradation, antibacterial ability, bioactivity and cytotoxicity. RSC Adv. 2015, 5, 72288–72299. [Google Scholar] [CrossRef]
- Liao, C.Z.; Wong, H.M.; Yeung, K.W.; Tjong, S.C. The development, fabrication and material characterization of polypropylene composites reinforced with carbon nanofiber and hydroxyapatite nanorod hybrid fillers. Int. J. Nanomed. 2014, 9, 1299–1310. [Google Scholar] [CrossRef]
- Liao, C.Z.; Li, K.; Wong, H.M.; Tong, W.Y.; Yeung, K.W.K.; Tjong, S.C. Novel polypropylene biocomposites reinforced with carbon nanotubes and hydroxyapatite nanorods for bone replacements. Mater. Sci. Eng. C 2013, 13, 1380–1388. [Google Scholar] [CrossRef]
- Tjong, S.C. Nanocrystalline Materials: Their Synthesis-Structure-Property Relationships and Applications, 2nd ed.; Elsevier: London, UK, 2013; ISBN 9780124077966. [Google Scholar]
- Ng, C.T.; Baeg, G.H.; Yu, L.E.; Ong, C.N.; Bay, B.H. Biomedical applications of nanomaterials as therapeutics. Curr. Med. Chem. 2018, 25, 1409–1419. [Google Scholar] [CrossRef]
- Kravets, V.; Almemar, Z.; Jiang, K.; Culhane, K.; Machado, R.; Hagen, G.; Kotko, A.; Dmytruk, I.; Spendier, K.; Pinchuk, A. Imaging of biological cells using luminescent silver nanoparticles. Nanoscale Res. Lett. 2016, 11, 30. [Google Scholar] [CrossRef]
- Elahi, N.; Kamali, M.; Baghersad, M.H. Recent biomedical applications of gold nanoparticles: A review. Talanta 2018, 184, 537–556. [Google Scholar] [CrossRef] [PubMed]
- Benyettou, F.; Rezgui, R.; Ravaux, F.; Jaber, T.; Blumer, K.; Jouiad, M.; Motte, L.; Olsen, J.C.; Platas-Iglesias, C.; Magzoub, M.; et al. Synthesis of silver nanoparticles for the dual delivery of doxorubicin and alendronate to cancer cells. J. Mater. Chem. B 2015, 3, 7237–7245. [Google Scholar] [CrossRef]
- Kokura, S.; Handa, O.; Takagi, T.; Ishikawa, T.; Naito, Y.; Yoshikawa, T. Silver nanoparticles as a safe preservative for use in cosmetics. Nanomedicine 2010, 6, 570–574. [Google Scholar] [CrossRef] [PubMed]
- Dakal, T.C.; Kumal, N.; Majumdal, R.; Yadav, V. Mechanistic basis of antimicrobial actions of silver nanoparticles. Front. Microbiol. 2016, 7, 1831. [Google Scholar] [CrossRef]
- D’Agostino, A.; Taglietti, A.; Desando, R.; Bini, M.; Patrini, M.; Dacarro, G.; Cucca, L.; Pallavicini, P.; Grisoli, P. Bulk surfaces coated with triangular silver nanoplates: Antibacterial action based on silver release and photo-thermal effect. Nanomaterials 2017, 7, 7. [Google Scholar] [CrossRef]
- Burdusel, A.C.; Gherasim, O.; Grumezescu, A.M.; Mogoanta, L.; Ficai, A.; Andronescu, E. Biomedical applications of silver nanoparticles: An up-to-date overview. Nanomaterials 2018, 8, 681. [Google Scholar] [CrossRef]
- Orlowski, P.; Zmigrodzka, M.; Tomaszewska, E.; Ranoszek-Soliwoda, K.; Czupryn, M.; Antos-Bielska, M.; Szemraj, J.; Celichowski, C.; Grobelny, J.; Krzyzowska, M. Tannic acid-modified silver nanoparticles for wound healing: The importance of size. Int. J. Nanomed. 2018, 13, 991–1007. [Google Scholar] [CrossRef] [PubMed]
- Konop, M.; Damps, T.; Misicka, A.; Rudnicka, L. Certain aspects of silver and silver nanoparticles in wound care: A minireview. J. Nanomater. 2016, 7614753. [Google Scholar] [CrossRef]
- Liu, C.; Shen, J.; Liao, C.Z.; Yeung, K.W.; Tjong, S.C. Novel electrospun polyvinylidene fluoride-graphene oxide-silver nanocomposite membranes with protein and bacterial antifouling characteristics. Express Polym. Lett. 2018, 12, 365–382. [Google Scholar] [CrossRef]
- Tian, J.; Wong, K.K.; Ho, C.M.; Lok, C.N.; Yu, W.Y.; Che, C.M.; Cliu, J.F.; Tam, P.K. Topical delivery of silver nanoparticles promotes wound healing. ChemMedChem 2007, 2, 129–136. [Google Scholar] [CrossRef] [PubMed]
- Keat, C.L.; Aziz, A.; Eid, A.M.; Elmarzugi, N.A. Biosynthesis of nanoparticles and silver nanoparticles. Bioresour. Bioprocess. 2015, 2, 47. [Google Scholar] [CrossRef]
- Chernousova, S.; Epple, M. Silver as antibacterial agent: Ion, nanoparticle and metal. Angew. Chem. Int. Ed. 2013, 52, 1636–1653. [Google Scholar] [CrossRef] [PubMed]
- Boca, S.C.; Potara, M.; Gabudean, A.; Juhem, A.; Baldeck, P.L.; Astilean, S. Chitosan-coated triangular silver nanoparticles as a novel class of biocompatible, highly effective photothermal transducers for in vitro cancer cell therapy. Cancer Lett. 2011, 311, 131–140. [Google Scholar] [CrossRef] [PubMed]
- Boca, S.; Potara, M.; Simon, T.; Juhem, A.; Baldeck, P.; Astilean, S. Folic acid-conjugated, SERS-labeled silver nanotriangles for multimodal detection and targeted photothermal treatment on human ovarian cancer cells. Mol. Pharm. 2014, 11, 391–399. [Google Scholar] [CrossRef] [PubMed]
- Alarcon, E.I.; Vulesevic, B.; Argawal, A.; Ross, A.; Bejjani, P.; Podrebarac, J.; Ravichandran, R.; Phopase, J.; Suuronen, E.J.; Griffith, M. Coloured cornea replacements with anti-infective properties: Expanding the safe use of silver nanoparticles in regenerative medicine. Nanoscale 2016, 8, 6484–6489. [Google Scholar] [CrossRef] [PubMed]
- Rigo, C.; Ferroni, L.; Tocco, I.; Roman, M.; Munivrana, I.; Gardin, C.; Cairns, W.R.; Vindigni, V.; Azzena, B.; Barbante, C. Active silver nanoparticles for wound healing. Int. J. Mol. Sci. 2013, 14, 4817–4840. [Google Scholar] [CrossRef]
- Liu, X.; Lee, P.Y.; Ho, C.M.; Lui, V.C.; Chen, Y.; Chi, C.M.; Tam, P.K.; Wong, K.Y. Silver nanoparticles mediate differential responses in keratinocytes and fibroblasts during skin wound healing. ChemMedChem 2010, 5, 468–475. [Google Scholar] [CrossRef]
- Pallavicini, P.; Arciola, C.R.; Bertoglio, F.; Curtosi, S.; Dacarro, G.; D’Agostino, A.; Ferrari, F.; Merli, D.; Milanese, C.; Rossi, S.; et al. Silver nanoparticles synthesized and coated with pectin: An ideal compromise for anti-bacterial and anti-biofilm action combined with wound-healing properties. J. Colloid Interface Sci. 2017, 498, 271–281. [Google Scholar] [CrossRef]
- Tang, B.; Li, J.; Hou, X.; Afrin, T.; Sun, L.; Wang, X. Colorful and antibacterial silk fiber from anisotropic silver nanoparticles. Ind. Eng. Chem. Res. 2013, 52, 4556–4563. [Google Scholar] [CrossRef]
- Vukoje, I.; Lazic, V.; Vodnik, V.; Mitric, M.; Jokic, B.; Ahrenkiel, S.P.; Nedeljkovic, J.M.; Radetic, M. The influence of triangular silver nanoplates on antimicrobial activity and color of cotton fabrics pretreated with chitosan. J. Mater. Sci. 2014, 49, 4453–4460. [Google Scholar] [CrossRef]
- Nowack, B.; Krug, H.F.; Height, M. 120 Years of nanosilver history: Implications for policy makers. Environ. Sci. Technol. 2011, 45, 1177–1183. [Google Scholar] [CrossRef] [PubMed]
- Kedziora, A.; Speruda, M.; Krzyzewska, E.; Rybka, J.; LukowiK, A.; Bugla-Płoskonska, G. Similarities and differences between silver ions and silver in nanoforms as antibacterial agents. Int. J. Mol. Sci. 2018, 19, 444. [Google Scholar] [CrossRef] [PubMed]
- Pallavicini, P.; Dacarro, G.; Taglietti, A. Self-assembled monolayers of silver nanoparticles: From intrinsic to switchable inorganic antibacterial surfaces. Eur. J. Inorg. Chem. 2018, 2018, 4846–4855. [Google Scholar] [CrossRef]
- Taglietti, A.; Fernandez, Y.A.; Amato, E.; Cucca, L.; Dacarro, G.; Grisoli, P.; Necchi, V.; Pallavicini, P.; Pasotti, L.; Patrini, M. Antibacterial activity of glutathione-coated silver nanoparticles against gram positive and gram negative bacteria. Langmuir 2012, 28, 8140–8148. [Google Scholar] [CrossRef] [PubMed]
- Frolich, E.E.; Frolich, E. Cytotoxicity of nanoparticles contained in food on intestinal cells and the gut microbiota. Int. J. Mol. Sci. 2016, 17, 509. [Google Scholar] [CrossRef]
- Slavin, Y.N.; Asnis, J.; Hafeli, U.O.; Bach, H. Metal nanoparticles: Understanding the mechanisms behind antibacterial activity. J. Nanobiotechnol. 2017, 15, 65. [Google Scholar] [CrossRef]
- Gurunathan, S.; Choi, Y.Z.; Kim, J.H. Antibacterial efficacy of silver nanoparticles on endometritis caused by Prevotella melaninogenica and Arcanobacterum pyogenes in dairy cattle. Int. J. Mol. Sci. 2018, 19, 1210. [Google Scholar] [CrossRef]
- Baptista, P.V.; McCusker, M.P.; Carvalho, A.; Ferreira, D.A.; Mohan, N.; Martins, M.; Fernandes, A.R. Nano-strategies to fight multidrug resistant bacteria—“A battle of the titans”. Front. Microbiol. 2018, 9, 1441. [Google Scholar] [CrossRef]
- Katva, S.; Das, S.; Moti, H.S.; Jyoti, A.; Kaushik, S. Antibacterial synergy of silver nanoparticles with gentamicin and chloramphenicol against Enterococcus faecalis. Pharmacogn. Mag. 2018, 13, S828–S833. [Google Scholar] [CrossRef]
- Agnihotri, S.; Mukherji, S.; Mukherji, S. Size-controlled silver nanoparticles synthesized over the range 5–100 nm using the same protocol and their antibacterial efficacy. RSC Adv. 2014, 4, 3974–3983. [Google Scholar] [CrossRef]
- Hong, X.; Wen, J.; Xiong, X.; Hu, Y. Shape effect on the antibacterial activity of silver nanoparticles synthesized via a microwave-assisted method. Environ. Sci. Pollut. Res. 2016, 23, 4489–4497. [Google Scholar] [CrossRef] [PubMed]
- Raza, M.A.; Kanwal, Z.; Rauf, A.; Sabri, A.N.; Riaz, S.; Naseem, S. Size- and shape-dependent antibacterial studies of silver nanoparticles synthesized by wet chemical routes. Nanomaterials 2016, 6, 74. [Google Scholar] [CrossRef] [PubMed]
- Xia, X.; Zeng, J.; Moran, C.H.; Xia, Y. Recent developments in shape-controlled synthesis of silver nanocrystals. J. Phys. Chem. C 2012, 116, 21647–21656. [Google Scholar] [CrossRef] [PubMed]
- Hosseinidoust, Z.; Basenet, M.; van de Ven, T.G.; Tufenkji, N. One-pot green synthesis of anisotropic silver nanoparticles. Environ. Sci. Nano 2016, 3, 1259–1264. [Google Scholar] [CrossRef]
- Mitrano, D.M.; Rimmele, E.; Wichser, A.; Erni, R.; Height, M.; Nowack, B. Presence of nanoparticles in wash water from conventional silver and nano-silver textiles. ACS Nano 2014, 8, 7208–7219. [Google Scholar] [CrossRef] [PubMed]
- Syafiuddin, A.; Salmiati, A.; Hadibarata, T.; Kueh, A.B.; Salim, M.R.; Zaini, M.A. Silver nanoparticles in the water environment in Malaysia: Inspection, characterization, removal, modeling, and future perspective. Sci. Rep. 2018, 8, 986. [Google Scholar] [CrossRef] [PubMed]
- Miyayama, T.; Arai, Y.; Hirano, S. Health Effects of Silver Nanoparticles and Silver Ions. In Biological Effects of Fibrous and Particulate Substances; Otsuki, T., Yoshioka, Y., Holian, Y., Eds.; Springer: Tokyo, Japan, 2016; pp. 137–147. ISBN 978-4-431-55731-9. [Google Scholar]
- Carrola, J.; Bastos, V.; Jarak, I.; Oliveira-Silva, R.; Malheiro, E.; Daniel-da-Silva, A.L.; Oliveira, H.; Santos, C.; Gil, A.M.; Duarte, I.F. Metabolomics of silver nanoparticles toxicity in HaCaT cells: Structure-activity relationships and role of ionic silver and oxidative stress. Nanotoxicology 2016, 10, 1105–1117. [Google Scholar] [CrossRef] [PubMed]
- Kim, M.J.; Shin, S. Toxic effects of silver nanoparticles and nanowires on erythrocyte rheology. Food Chem. Toxicol. 2014, 67, 80–86. [Google Scholar] [CrossRef]
- Sabella, S.; Carney, R.P.; Brunetti, V.; Malvindi, M.A.; Al-Juffali, N.; Vecchio, G.; Janes, S.M.; Bakr, O.M.; Cingolani, R.; Stellacci, F.; et al. A general mechanism for intracellular toxicity of metal-containing nanoparticles. Nanoscale 2014, 6, 7052–7061. [Google Scholar] [CrossRef]
- Li, L.; Cui, J.; Liu, Z.; Zhou, X.; Li, Z.; Yu, Y.; Jia, Y.; Zuo, D.; Wu, Y. Silver nanoparticles induce SH-SY5Y cell apoptosis via endoplasmic reticulum- and mitochondrial pathways that lengthen endoplasmic reticulum–mitochondria contact sites and alter inositol-3-phosphate receptor function. Toxicol. Lett. 2018, 285, 156–167. [Google Scholar] [CrossRef]
- Sahu, S.C.; Zheng, J.; Graham, L.; Chen, L.; Ihrie, J.; Yourick, J.J.; Sprando, R.L. Comparative cytotoxicity of nanosilver in human liver HepG2 and colon Caco2 cells in culture. J. Appl. Toxicol. 2014, 34, 1155–1166. [Google Scholar] [CrossRef] [PubMed]
- Shi, J.; Sun, X.; Zou, X.; Li, J.; Liao, Y.; Du, M. Endothelial cell injury and dysfunction induced by silver nanoparticles through oxidative stress via IKK/NF-κB pathways. Biomaterials 2014, 35, 6657–6666. [Google Scholar] [CrossRef] [PubMed]
- Jiang, X.; Lu, C.; Tang, M.; Yang, Z.; Jia, W.; Ma, Y.; Jia, P.; Pei, D.; Wang, H. Nanotoxicity of silver nanoparticles on HEK293T cells: A combined study using biomechanical and biological techniques. ACS Omega 2018, 3, 6770–6778. [Google Scholar] [CrossRef] [PubMed]
- Vidanapathirana, A.K.; Thompson, L.C.; Herco, M.; Odom, J.; Sumner, S.J.; Fennell, T.R.; Brown, J.M.; Wingard, C.J. Acute intravenous exposure to silver nanoparticles during pregnancy induces particle size and vehicle dependent changes in vascular tissue contractility in Sprague Dawley rats. Reprod. Toxicol. 2018, 75, 10–22. [Google Scholar] [CrossRef] [PubMed]
- Alessandrini, F.; Vennemann, A.; Gschwendtner, S.; Neumann, A.U.; Rothballer, M.; Seher, T.; Wimmer, M.; Kublik, S.; Traidl-Hoffmann, C.; Schloter, M.; et al. Pro-inflammatory versus immunomodulatory effects of silver nanoparticles in the lung: The critical role of dose, size and surface modification. Nanomaterials 2017, 7, 300. [Google Scholar] [CrossRef] [PubMed]
- Trickler, W.; Lantz, S.M.; Murdock, R.C.; Schrand, A.M.; Robinson, B.L.; Newport, G.D.; Schalager, J.J.; Oldenburg, S.J.; Paule, M.G.; Slikker, W., Jr.; et al. Silver nanoparticle induced blood-brain barrier inflammation and increased permeability in primary brain microvessel endothelial cells. Toxicol. Sci. 2010, 118, 160–170. [Google Scholar] [CrossRef] [PubMed]
- Sokolowska, P.; Bialkowska, K.; Siatkowskaa, M.; Rosowski, M.; Kucinska, M.; Komorowski, P.; Makowski, K.; Walkowiak, B. Human brain endothelial barrier cells are distinctly less vulnerable to silver nanoparticles toxicity than human blood vessel cells—A cell-specific mechanism of the brain barrier? Nanomed. Nanotechnol. 2017, 13, 2127–2130. [Google Scholar] [CrossRef]
- Butler, K.S.; Peeler, D.J.; Casey, B.J.; Dair, B.J.; Elespuru, R.K. Silver nanoparticles: Correlating nanoparticle size and cellular uptake with genotoxicity. Mutagenesis 2015, 30, 577–591. [Google Scholar] [CrossRef]
- Jeong, Y.; Lim, D.W.; Choi, J. Assessment of size-dependent antimicrobial and cytotoxic properties of silver nanoparticles. Adv. Mater. Sci. Eng. 2014, 763807. [Google Scholar] [CrossRef]
- Dayem, A.A.; Hossain, M.K.; Lee, S.B.; Kim, K.; Saha, S.K.; Yang, G.M.; Choi, H.Y.; Cho, S.G. The role of reactive oxygen species (ROS) in the biological activities of metallic nanoparticles. Int. J. Mol. Sci. 2017, 18, 120. [Google Scholar] [CrossRef]
- Iravani, S.; Korbekandi, H.; Mirmohammadi, S.V.; Zolfaghari, B. Synthesis of silver nanoparticles: Chemical, physical and biological methods. Res. Pharm. Sci. 2014, 9, 385–406. [Google Scholar] [PubMed]
- Jung, J.; Oh, H.; Noh, H.; Ji, J.; Kim, S. Metal nanoparticle generation using a small ceramic heater with a local heating area. J. Aerosol. Sci. 2006, 37, 1662–1670. [Google Scholar] [CrossRef]
- Tsuji, T.; Iryo, K.; Watanabe, N.; Tsuji, M. Preparation of silver nanoparticles by laser ablation in solution: Influence of laser wavelength on particle size. Appl. Surf. Sci. 2002, 202, 80–85. [Google Scholar] [CrossRef]
- Perito, B.; Giorgetti, E.; Marsili, P.; Muniz-Miranda, M. Antibacterial activity of silver nanoparticles obtained by pulsed laser ablation in pure water and in chloride solution. Beilstein J. Nanotechnol. 2016, 7, 465–473. [Google Scholar] [CrossRef] [PubMed]
- Sportelli, M.C.; Izzi, M.; Volpe, A.; Clemente, M.; Picca, R.A.; Ancona, A.; Lugara, P.M.; Palazzo, G.; Cioffi, N. The pros and cons of the use of laser ablation synthesis for the production of silver nano-antimicrobials. Antibiotics 2018, 7, 67. [Google Scholar] [CrossRef] [PubMed]
- Sato-Berru, R.; Redon, R.; Vazquez-Olmos, A.; Saniger, J.M. Silver nanoparticles synthesized by direct photoreduction of metal salts. Application in surface-enhanced Raman spectroscopy. J. Raman Spectrosc. 2009, 40, 376–380. [Google Scholar] [CrossRef]
- Krol-Gracz, A.; Michalak, E.; Nowak, P.; Dyonizy, A. Photo-induced chemical reduction of silver bromide to silver nanoparticles. Cent. Eur. J. Chem. 2011, 9, 982–989. [Google Scholar] [CrossRef]
- Beyene, H.D.; Werkneh, A.A.; Bezabha, H.K.; Ambaye, T.G. Synthesis paradigm and applications of silver nanoparticles (AgNPs), a review. Sustain. Mater. Technol. 2017, 13, 18–23. [Google Scholar] [CrossRef]
- Pacioni, N.L.; Borsarelli, C.D.; Rey, V.; Veglia, A.V. Synthetic Routes for the Preparation of Silver Nanoparticles: A Mechanistic Perspective. In Silver nanoparticle Applications; Alarcon, E.I., Griffith, M., Udekwu, K.I., Eds.; Springer: Cham, Switzerland, 2015; pp. 13–46. ISBN 978-3-319-11261-9. [Google Scholar]
- Helmlinger, J.; Sengstock, C.; Groß-Heitfeld, C.; Mayer, C.; Schildhaue, T.A.; Koller, M.; Epple, M. Silver nanoparticles with different size and shape: Equal cytotoxicity, but different antibacterial effects. RSC Adv. 2016, 6, 18490–18501. [Google Scholar] [CrossRef]
- Ranoszek-Soliwoda, K.; Tomaszewska, E.; Socha, E.; Krzyczmonik, P.; Ignaczak, A.; Orlowski, P.; Krzyzowska, M.; Celichowski, G.; Grobeln, J. The role of tannic acid and sodium citrate in the synthesis of silver nanoparticles. J. Nanopart. Res. 2017, 19, 273. [Google Scholar] [CrossRef]
- Kytsya, A.; Bazylyak, L.; Hrynda, Y.; Horechyy, A.; Medvedevdkikh, Y. The kinetic rate law for the autocatalytic growth of citrate-stabilized silver nanoparticles. Int. J. Chem. Kinet. 2015, 47, 351–360. [Google Scholar] [CrossRef]
- Malassis, L.; Dreyfus, R.; Murphy, R.J.; Hough, L.A.; Donnio, B.; Murray, C.B. One-step green synthesis of gold and silver nanoparticles with ascorbic acid and their versatile surface post-functionalization. RSC Adv. 2016, 6, 33092–33100. [Google Scholar] [CrossRef]
- Gharibshahi, L.; Saion, E.; Gharibshahi, E.; Shaari, A.H.; Matori, K.A. Influence of poly(vinylpyrrolidone) concentration on properties of silver nanoparticles manufactured by modified thermal treatment method. PLoS ONE 2017, 12, e0186094. [Google Scholar] [CrossRef] [PubMed]
- Kvitek, L.; Panacek, A.; Soukupova, J.; Kolar, M.; Vecerova, R.; Prucek, R.; Holecova, M.; Zboril, R. Effect of surfactants and polymers on stability and antibacterial activity of silver nanoparticles (NPs). J. Phys. Chem. C 2008, 112, 5825–5834. [Google Scholar] [CrossRef]
- Sun, Y. Controlled synthesis of colloidal silver nanoparticles in organic solutions: Empirical rules for nucleation engineering. Chem. Soc. Rev. 2013, 42, 2497–2511. [Google Scholar] [CrossRef] [PubMed]
- Fievet, F.; Ammar-Merah, S.; Brayner, R.; Chao, F.; Giraud, M.; Mammeri, F.; Peron, J.; Piquemal, J.Y.; Sicard, L.; Viau, G. The polyol process: A unique method for easy access to metal nanoparticles with tailored sizes, shapes and compositions. Chem. Soc. Rev. 2018, 47, 5187–5233. [Google Scholar] [CrossRef] [PubMed]
- Dang, T.M.; Le, T.T.; Fribourg-Blanc, E.; Dang, M.C. Influence of surfactant on the preparation of silver nanoparticles by polyol method. Adv. Nat. Sci. Nanosci. Nanotechnol. 2012, 3, 035004. [Google Scholar] [CrossRef]
- Nguyen, N.T.; Nguyen, B.H.; Ba, D.T.; Pham, D.G.; Kahi, T.V.; Nguyen, L.T.; Tran, L.D. Microwave-assisted synthesis of silver nanoparticles using chitosan: A novel approach. Mater. Manuf. Process. 2014, 29, 418–421. [Google Scholar] [CrossRef]
- Ajitha, B.; Ashok Kumar Reddy, Y.; Sreedhara Reddy, P. Enhanced antimicrobial activity of silver nanoparticles with controlled particle size by pH variation. Powder Technol. 2015, 269, 110–117. [Google Scholar] [CrossRef]
- Zhang, Y.; Newton, B.; Lewis, E.; Fu, P.P.; Kafoury, R.; Ray, P.C.; Yu, H. Cytotoxicity of organic surface coating agents used for nanoparticles synthesis and stability. Toxicol. In Vitro 2015, 29, 762–768. [Google Scholar] [CrossRef]
- Alam, M.S.; Siddiq, A.M.; Balamurugan, S.; Mandal, A.B. Role of cloud point of the capping agent (nonionic surfactant, Triton X-100) on the synthesis of silver nanoparticles. J. Disper. Sci. Technol. 2016, 37, 853–859. [Google Scholar] [CrossRef]
- Sosa, Y.D.; Laberelo, M.; Trevini, M.E.; Saade, H.; Lopez, R.G. High-yield synthesis of silver nanoparticles by precipitation in a high-aqueous phase content reverse microemulsion. J. Nanomater. 2010, 2010, 392572. [Google Scholar] [CrossRef]
- Rivera-Rangela, R.D.; Gonzalez-Muñoza, M.P.; Avila-Rodriguez, M.; Razo-Lazcano, T.A.; Solans, C. Green synthesis of silver nanoparticles in oil-in-water microemulsion and nano-emulsion using geranium leaf aqueous extract as a reducing agent. Colloids Surf. A 2018, 536, 60–67. [Google Scholar] [CrossRef]
- Das, M.; Patowary, K.; Vidya, R.; Malipeddi, H. Microemulsion synthesis of silver nanoparticles using biosurfactant extracted from Pseudomonas aeruginosa MKVIT3 strain and comparison of their antimicrobial and cytotoxic activities. IET Nanobiotechnol. 2016, 10, 411–418. [Google Scholar] [CrossRef] [PubMed]
- Baig, N.; Nadagouda, M.N.; Polshettiwar, V. Sustainable Synthesis of Metal Oxide Nanostructures. In Sustainable Inorganic Chemistry; Atwood, D.A., Ed.; Wiley: Hoboken, NJ, USA, 2016; pp. 483–494. ISBN 978-1-118-70342-7. [Google Scholar]
- Lu, Y.; Zhang, C.; Hao, R.; Zhang, D.; Fu, Y.; Moeendarbari, S. Morphological transformations of silver nanoparticles in seedless photochemical synthesis. Mater. Res. Exp. 2016, 3, 055014. [Google Scholar] [CrossRef]
- Xu, G.N.; Qiao, X.L.; Qiu, X.L.; Chen, J.G. Preparation and characterization of stable monodisperse silver nanoparticles via photoreduction. Colloids Surf. A 2008, 320, 222–226. [Google Scholar] [CrossRef]
- Omrani, A.A.; Taghavinia, N. Photo-induced growth of silver nanoparticles using UV sensitivity of cellulose fibers. Appl. Surf. Sci. 2012, 258, 2373–2377. [Google Scholar] [CrossRef]
- Ashraf, J.M.; Ansari, M.A.; Khan, H.M.; Alzohairy, M.A.; Choi, I. Green synthesis of silver nanoparticles and characterization of their inhibitory effects on AGEs formation using biophysical techniques. Sci. Rep. 2016, 6, 20414. [Google Scholar] [CrossRef]
- Siddiqi, K.S.; Husen, A.; Rao, R.A. A review on biosynthesis of silver nanoparticles and their biocidal properties. J. Nanobiotechnol. 2018, 16, 14. [Google Scholar] [CrossRef]
- Vasquez, R.D.; Apostol, J.G.; Leon, J.D.; Mariano, J.D.; Mirhan, C.N.; Pangan, S.S.; Reyes, A.G.; Zamora, E.T. Polysaccharide-mediated green synthesis of silver nanoparticles from Sargassum siliquosum J.G. Agardh: Assessment of toxicity and hepatoprotective activity. OpenNano 2016, 1, 16–24. [Google Scholar] [CrossRef]
- Logaranjan, K.; Raiza, A.J.; Gopinath, S.C.; Chen, Y.; Pandia, K. Shape- and size-controlled synthesis of silver nanoparticles using aloe vera plant extract and their antimicrobial activity. Nanoscale Res. Lett. 2016, 11, 520. [Google Scholar] [CrossRef] [PubMed]
- Verma, A.; Mehata, M.S. Controllable synthesis of silver nanoparticles using Neem leaves and their antimicrobial activity. J. Radiat. Res. Appl. Sci. 2016, 9, 109–115. [Google Scholar] [CrossRef]
- Singh, R.; Rawat, D.; Isha. Microwave-assisted synthesis of silver nanoparticles from Origanum majorana and citrus sinensis leaf and their antibacterial activity: A green chemistry approach. Bioresour. Bioprocess. 2016, 3, 14. [Google Scholar] [CrossRef]
- Venkatesan, J.; Kim, S.K.; Shim, M.S. Antimicrobial, antioxidant, and anticancer activities of biosynthesized silver nanoparticles using marine algae Ecklonia cava. Nanomaterials 2016, 6, 235. [Google Scholar] [CrossRef] [PubMed]
- Sanyasi, S.; Majhi, R.K.; Kumar, S.; Mishra, M.; Ghosh, A.; Suar, M.; Satyam, P.V.; Mohapatra, H.; Goswami, C.; Goswami, L. Polysaccharide-capped silver nanoparticles inhibit biofilm formation and eliminate multidrug-resistant bacteria by disrupting bacterial cytoskeleton with reduced cytotoxicity towards mammalian cells. Sci. Rep. 2016, 6, 24929. [Google Scholar] [CrossRef]
- Xia, Q.H.; Ma, Y.J.; Wang, J.W. Biosynthesis of silver nanoparticles using Taxus yunnanensis Callus and their antibacterial activity and cytotoxicity in human cancer cells. Nanomaterials 2016, 6, 160. [Google Scholar] [CrossRef]
- Skandalis, N.; Dimopoulou, A.; Georgopoulou, A.; Gallios, N.; Papadopoulos, D.; Tsipas, D.; Theologidis, I.; Michailidis, N.; Chatzinikolaidou, M. The effect of silver nanoparticles size, produced using plant extract from Arbutus unedo, on their antibacterial efficacy. Nanomaterials 2017, 7, 178. [Google Scholar] [CrossRef]
- Mohammed, A.E.; Al-Qahtani, A.; al-Mutairi, A.; Al-Shamri, B.; Aabed, K. Antibacterial and cytotoxic potential of biosynthesized silver nanoparticles by some plant extracts. Nanomaterials 2018, 8, 382. [Google Scholar] [CrossRef]
- Chain, R.B.; Monzo-Cabrera, J.; Solyom, K. Microwave-Assisted Plant Extraction Processes. In Alternative Energy Sources for Green Chemistry; Stefanidis, G., Stankiewicz, A., Eds.; RSC Publishing: London, UK, 2016; Chapter 2; pp. 34–63. ISBN 978-1-78262-140-9. [Google Scholar]
- Peng, H.; Yang, A.; Xiong, J. Green, microwave assisted synthesis of silver nanoparticles using bamboo hemicelluloses and glucose in an aqueous medium. Carbohydr. Polym. 2013, 91, 348–355. [Google Scholar] [CrossRef]
- Kahrilas, G.A.; Wally, L.M.; Fredrick, S.J.; Hiskey, M.; Prieto, A.L.; Owens, J.E. Microwave-assisted green synthesis of silver nanoparticles using orange peel extract. ACS Sustain. Chem. Eng. 2014, 2, 367–376. [Google Scholar] [CrossRef]
- Ali, K.; Ahmed, B.; Dwivedi, S.; Saquib, Q.; Al-Kedhairy, A.A.; Musarrat, J. Microwave accelerated green synthesis of stable silver nanoparticles with Eucalyptus globulus leaf extract and their antibacterial and antibiofilm activity on clinical isolates. PLoS ONE 2015, 10, e0131178. [Google Scholar] [CrossRef] [PubMed]
- Yuan, Y.G.; Peng, Q.L.; Gurunathan, S. Effects of silver nanoparticles on multiple drug-resistant strains of staphylococcus aureus and pseudomonas aeruginosa from mastitis-infected goats: An alternative approach for antimicrobial therapy. Int. J. Mol. Sci. 2017, 18, 569. [Google Scholar] [CrossRef] [PubMed]
- Fatimah, I. Green synthesis of silver nanoparticles using extract of Parkia speciosa Hassk pods assisted by microwave irradiation. J. Adv. Res. 2016, 7, 961–969. [Google Scholar] [CrossRef] [PubMed]
- Velusamy, P.; Su, C.H.; Kumar, G.V.; Adhikary, S.; Pandian, K.; Gopinath, S.C.; Chen, Y.; Anbu, P. Biopolymers regulate silver nanoparticle under microwave irradiation for effective antibacterial and antibiofilm activities. PLoS ONE 2016, 11, e0157612. [Google Scholar] [CrossRef] [PubMed]
- Kumar, S.V.; Bafana, A.P.; Pawar, P.; Rahman, A.; Dahoumane, S.; Jeffreys, C.S. High conversion synthesis of <10 nm starch-stabilized silver nanoparticles using microwave technology. Sci. Rep. 2018, 8, 5106. [Google Scholar] [CrossRef] [PubMed]
- Meng, Y.Z.; Tjong, S.C.; Hay, A.S.; Wang, S.J. Synthesis and proton conductivities of phosphonic acid containing poly-(arylene ether)s. J. Polym. Sci. A Polym. Chem. 2001, 39, 3218–3226. [Google Scholar] [CrossRef]
- Meng, Y.Z.; Hay, A.S.; Jian, X.G.; Tjong, S.C. Synthesis and properties of poly (aryl ether sulfone)s containing the phthalazinone moiety. J. Appl. Polym. Sci. 1998, 68, 137–143. [Google Scholar] [CrossRef]
- Kelly, F.M.; Johnston, J.H. Colored and functional silver nanoparticle–wool fiber composites. ACS Appl. Mater. Interfaces 2011, 3, 1083–1092. [Google Scholar] [CrossRef]
- Tjong, S.C.; Meng, Y.Z. Morphology and mechanical characteristics of compatibilized polyamide 6-liquid crystalline polymer composites. Polymer 1997, 38, 4609–4615. [Google Scholar] [CrossRef]
- Meng, Y.Z.; Tjong, S.C. Rheology and morphology of compatibilized polyamide 6 blends containing liquid crystalline copolyesters. Polymer 1998, 39, 99–107. [Google Scholar] [CrossRef]
- Liang, J.Z.; Li, R.K.Y.; Tjong, S.C. Tensile properties and morphology of PP/EPDM/glass bead ternary composites. Polym. Compos. 1999, 20, 413–422. [Google Scholar] [CrossRef]
- Li, R.K.Y.; Liang, J.Z.; Tjong, S.C. Morphology and dynamic mechanical properties of glass beads filled 1139 low density polyethylene composites. J. Mater. Process. Technol. 1998, 79, 59–65. [Google Scholar] [CrossRef]
- Tjong, S.C.; Liu, S.L.; Li, R.K.Y. Mechanical properties of injection moulded blends of polypropylene with thermotropic liquid crystalline polymer. J. Mater. Sci. 1996, 31, 479–484. [Google Scholar] [CrossRef]
- He, L.; Tjong, S.C. Facile synthesis of silver-decorated reduced graphene oxide as a hybrid filler material for electrically conductive polymer composites. RSC Adv. 2015, 5, 15070–15076. [Google Scholar] [CrossRef]
- Tjong, S.C.; Meng, Y.Z. Preparation and characterization of melt-compounded polyethylene/vermiculite nanocomposites. J. Polym. Sci. B Polym. Phys. 2003, 41, 1476–1484. [Google Scholar] [CrossRef]
- Liu, C.; Chan, K.W.; Shen, J.; Liao, C.Z.; Yeung, K.W.K.; Tjong, S.C. Polyetheretherketone hybrid composites with bioactive nanohydroxyapatite and multiwalled carbon nanotube fillers. Polymers 2016, 8, 425. [Google Scholar] [CrossRef]
- Li, K.; Cui, S.; Hua, J.; Zhou, Y.; Liu, Y. Crosslinked pectin nanofibers with well-dispersed Ag nanoparticles: Preparation and characterization. Carbohydr. Polym. 2018, 199, 68–74. [Google Scholar] [CrossRef] [PubMed]
- Stauffer, S.R.; Peppast, N.A. Poly(vinyl alcohol) hydrogels prepared by freezing-thawing cyclic processing. Polymer 1992, 33, 3932–3936. [Google Scholar] [CrossRef]
- Hassan, C.M.; Peppas, N.A. Structure and morphology of freeze/thawed PVA hydrogels. Macromolecules 2000, 33, 2472–2479. [Google Scholar] [CrossRef]
- Figueroa-Pizano, M.D.; Velaz, I.; Penas, F.J.; Zavala-Rivera, P.; Rosas-Durazo, A.J.; Maldonado-Arce, A.D.; Martinez-Barbos, M.E. Effect of freeze-thawing conditions for preparation of chitosan-poly (vinyl alcohol) hydrogels and drug release studies. Carbohydr. Polym. 2018, 195, 476–485. [Google Scholar] [CrossRef]
- Loo, C.Y.; Young, P.M.; Lee, W.H.; Cavaliere, R.; Witchurch, C.B.; Rohanizadeh, R. Non-cytotoxic silver nanoparticle-polyvinyl alcohol hydrogels with anti-biofilm activity: Designed as coatings for endotracheal tube materials. Biofouling 2014, 30, 773–788. [Google Scholar] [CrossRef] [PubMed]
- Agnihotri, S.; Mukherji, S. Antimicrobial chitosan–PVA hydrogel as a nanoreactor and immobilizing matrix for silver nanoparticles. Appl. Nanosci. 2012, 2, 179–188. [Google Scholar] [CrossRef]
- El-Shishtawy, R.M.; Asiri, A.M.; Abdelwahed, N.A.; Al-Otaibi, M.M. In situ production of silver nanoparticle on cotton fabric and its antimicrobial evaluation. Cellulose 2011, 18, 75–82. [Google Scholar] [CrossRef]
- Babaahmadi, V.; Montazer, A. A new route to synthesis silver nanoparticles on polyamide fabric using stannous chloride. J. Text. Inst. 2015, 106, 970–977. [Google Scholar] [CrossRef]
- Shinde, V.V.; Jadhav, P.R.; Kim, J.H.; Patil, P.S. One-step synthesis and characterization of anisotropic silver nanoparticles: Application for enhanced antibacterial activity of natural fabric. J. Mater. Sci. 2013, 48, 8393–8401. [Google Scholar] [CrossRef]
- Babu, K.F.; Dhandapani, P.; Maruthamuthu, S.; Kulandainathan, M.A. One pot synthesis of polypyrrole silver nanocomposite on cotton fabrics for multifunctional property. Carbohydr. Polym. 2012, 90, 1557–1563. [Google Scholar] [CrossRef] [PubMed]
- Kim, T.S.; Cha, J.R.; Gong, M.S. Investigation of the antimicrobial and wound healing properties of silver nanoparticle-loaded cotton prepared using silver carbamate. Text. Res. J. 2018, 88, 766–776. [Google Scholar] [CrossRef]
- Montazer, M.; Shamei, A.; Alimohammadi, F. Synthesis of nanosilver on polyamide fabric using silver/ammonia complex. Mater. Sci. Eng. C 2014, 38, 170–176. [Google Scholar] [CrossRef] [PubMed]
- Montazer, M.; Shamei, A.; Alimohammadi, F. Synthesizing and stabilizing silver nanoparticles on polyamide fabric using silver-ammonia/PVP/UVC. Prog. Org. Coat. 2012, 75, 379–385. [Google Scholar] [CrossRef]
- Breitwiesera, D.; Moghaddama, M.M.; Spirkc, S.; Baghbanzadeha, M.; Pivecd, T.; Fasl, H.; Ribitscha, V.; Kappe, C.O. In situ preparation of silver nanocomposites on cellulosic fibers–Microwave vs. conventional heating. Carbohydr. Polym. 2013, 94, 677–686. [Google Scholar] [CrossRef]
- Choudhary, U.; Dey, E.; Bhattacharyya, R.; Ghosh, S.K. A brief review on plasma treatment of textile materials. Adv. Res. Text. Eng. 2018, 3, 1019. [Google Scholar]
- Zille, A.; Fernandes, M.M.; Francesko, A.; Tzanov, T.; Fernandes, M.; Oliveira, F.R.; Almeida, L.; Amorim, T.; Carneiro, N.; Esteves, M.F.; et al. Size and aging effects on antimicrobial efficiency of silver nanoparticles coated on polyamide fabrics activated by atmospheric DBD plasma. ACS Appl. Mater. Interfaces 2015, 7, 13731–13744. [Google Scholar] [CrossRef] [PubMed]
- Ilic, V.; Saponjic, Z.; Vodnik, V.; Lazovic, S.; Dimitrijevic, S.; Jovancic, P.; Nedeljkovic, J.M.; Radetic, M. Bactericidal efficiency of silver nanoparticles deposited onto radio frequency plasma pretreated polyester fabrics. Ind. Eng. Chem. Res. 2010, 49, 7287–7293. [Google Scholar] [CrossRef]
- Sondi, I.; Salopek-Sondi, B. Silver nanoparticles as antimicrobial agent: A case study on E. coli as a model for Gram negative bacteria. J. Colloid Interf. Sci. 2004, 275, 177–182. [Google Scholar] [CrossRef] [PubMed]
- Gahlawat, G.; Shikha, S.; Chaddha, B.S.; Chaudhuri, S.R.; Mayilraj, S.; Choudhury, A.R. Microbial glycolipoprotein-capped silver nanoparticles as emerging antibacterial agents against cholera. Microb. Cell Fact. 2016, 15, 25. [Google Scholar] [CrossRef] [PubMed]
- Lok, C.N.; Ho, C.M.; Chen, R.; He, Q.; Yu, W.Y.; Sun, H.; Tam, P.K.; Chiu, J.F.; Che, C.M. Proteomic analysis of the mode of antibacterial action of silver nanoparticles. J. Proteome Res. 2006, 5, 916–924. [Google Scholar] [CrossRef] [PubMed]
- Barros, C.H.; Fulaz, S.; Stanisic, D.; Tasic, L. Biogenic nanosilver against multidrug-resistant bacteria (MRDB). Antibiotics 2018, 7, 69. [Google Scholar] [CrossRef]
- Morones, J.R.; Elechiguerra1, J.L.; Camacho, A.; Holt, K.; Kouri, J.B.; Ramirez, J.T.; Yacaman, M.J. The bactericidal effect of silver nanoparticles. Nanotechnology 2005, 16, 2346–2353. [Google Scholar] [CrossRef]
- Tjong, S.C.; Hoffman, R.W.; Yeager, E.B. Electron and ion spectroscopic iron-chromium alloys. J. Electrochem. Soc. 1982, 129, 1662–1668. [Google Scholar] [CrossRef]
- Tjong, S.C.; Yeager, E. ESCA and SIMS studies of the passive film on iron. J. Electrochem. Soc. 1981, 128, 2251–2254. [Google Scholar] [CrossRef]
- Behra, R.; Sigg, L.; Clift, M.J.; Herzog, F.; Minghetti, M.; Johnston, B.; Petri-Fink, A.; Rothen-Rutishauser, B. Bioavailability of silver nanoparticles and ions: From a chemical and biochemical perspective. J. R. Soc. Interface 2013, 10, 20130396. [Google Scholar] [CrossRef]
- Xiu, Z.M.; Zhang, Q.B.; Puppala, H.L.; Colvin, V.L.; Alvarez, P.J. Negligible particle-specific antibacterial activity of silver nanoparticles. Nano Lett. 2012, 12, 4271–4275. [Google Scholar] [CrossRef]
- Jung, W.K.; Koo, H.C.; Kim, K.W.; Shin, S.; Kim, S.Y.; Park, Y.H. Antibacterial activity and mechanism of action of the silver ion in Staphylococcus aureus and Escherichia coli. Appl. Environ. Microbiol. 2008, 74, 2171–2178. [Google Scholar] [CrossRef]
- Hsueh, Y.H.; Lin, K.S.; Ke, W.J.; Hsieh, C.T.; Chiang, C.L.; Tzou, D.Y.; Liu, S.T. The antimicrobial properties of silver nanoparticles in bacillus subtilis are mediated by released Ag+ ions. PLoS ONE 2015, 10, e0144306. [Google Scholar] [CrossRef]
- Khalandi, B.; Asadi, N.; Milani, M.; Davaran, S.; Abadi, A.J.; Abasi, E.; Akbarzadeh, A. A review on potential role of silver nanoparticles and possible mechanisms of their action on bacteria. Drug Res. 2016, 67, 70–76. [Google Scholar] [CrossRef]
- Bondarenko, O.; Ivask, A.; Kakinen, A.; Kurvet, I.; Kahru, A. Particle-cell contact enhances Antibacterial sctivity of silver nanoparticles. PLoS ONE 2013, 8, e64060. [Google Scholar] [CrossRef]
- Ivask, A.; ElBadawy, A.; Kaweeteerawat, C.; Boren, D.; Fischer, H.; Ji, Z.; Chang, C.H.; Liu, R.; Tolaymat, T.; Telesca, D.; et al. Toxicity mechanisms in Escherichia coli vary for silver nanoparticles and differ from ionic silver. ACS Nano 2014, 8, 374–386. [Google Scholar] [CrossRef]
- Quinteros, M.A.; Aristizabal, V.C.; Dalmasso, P.R.; Paraje, M.G.; Paez, P.L. Oxidative stress generation of silver nanoparticles in three bacterial genera and its relationship with the antimicrobial activity. Toxicol. In Vitro 2016, 36, 216–223. [Google Scholar] [CrossRef]
- Pareek, V.; Gupta, R.; Panwar, J. Do physico-chemical properties of silver nanoparticles decide their interaction with biological media and bactericidal action? A review. Mater. Sci. Eng. C 2018, 90, 739–749. [Google Scholar] [CrossRef]
- Gao, M.; Sun, L.; Wang, Z.; Zhao, Y. Controlled synthesis of Ag nanoparticles with different morphologies and their antibacterial properties. Mater. Sci. Eng. C 2013, 33, 397–404. [Google Scholar] [CrossRef]
- Abbaszadegan, A.; Ghahramani, Y.; Gholami, A.; Hemmateenejad, B.; Dorostkar, S.; Nabavizadeh, M.; Shargh, H. The effect of charge at the surface of silver nanoparticles on antimicrobial activity against Gram-positive and Gram-negative bacteria: A preliminary study. J. Nanomater. 2015, 2015, 720654. [Google Scholar] [CrossRef]
- Lu, Z.; Rong, K.; Li, J.; Yang, H.; Chen, R. Size-dependent antibacterial activities of silver nanoparticles against oral anaerobic pathogenic bacteria. J. Mater. Sci. Mater. Med. 2013, 24, 1465–1471. [Google Scholar] [CrossRef] [PubMed]
- Lee, H.J.; Lee, S.G.; Oh, E.J.; Chung, H.Y.; Han, S.I.; Kim, E.J.; Seo, S.Y.; Ghim, H.D.; Yeum, J.H.; Choi, J.H. Antimicrobial polyethyleneimine-silver nanoparticles in a stable colloidal dispersion. Colloids Surf. B 2011, 88, 505–511. [Google Scholar] [CrossRef] [PubMed]
- Kim, D.H.; Park, J.C.; Jeon, G.E.; Kim, C.S.; Seo, J.H. Effect of the size and shape of silver nanoparticles on bacterial growth and metabolism by monitoring optical density and fluorescence intensity. Biotechnol. Bioprocess Eng. 2017, 22, 210–217. [Google Scholar] [CrossRef]
- Pal, S.; Tak, Y.K.; Song, J.M. Does the antibacterial activity of silver nanoparticles depend on the shape of the nanoparticle? A study of the Gram-negative bacterium Escherichia coli. Appl. Environ. Microbiol. 2007, 73, 1712–1720. [Google Scholar] [CrossRef] [PubMed]
- Acharya, D.; Singha, K.M.; Pandey, P.; Mohanta, B.; Rajkumari, J.; Singha, L.P. Shape dependent physical mutilation and lethal effects of silver nanoparticles on bacteria. Sci. Rep. 2018, 8, 201. [Google Scholar] [CrossRef] [PubMed]
- Kidd, T.J.; Mills, G.; Sa-Pessoa, J.; Dumigan, A.; Frank, C.G.; Insua, J.; Ingram, R.; Hobley, L.; Bengoeche, J.A. A Klebsiella pneumoniae antibiotic resistance mechanism that subdues host defenses and promotes virulence. EMBO Mol. Med. 2017, 9, 430–447. [Google Scholar] [CrossRef] [PubMed]
- Van der Wal, A.; Norde, W.; Zehnder, A.; Lyklema, J. Determination of the surface charge in the cell walls of gram-positive bacteria. Colloid Surf. B 1997, 9, 81–100. [Google Scholar] [CrossRef]
- Badawy, A.M.; Silva, R.; Morris, B.; Scheckel, K.G.; Suidan, M.T.; Tolaymat, T.M. Surface charge-dependent toxicity of silver nanoparticles. Environ. Sci. Technol. 2011, 45, 283–287. [Google Scholar] [CrossRef] [PubMed]
- Rivero, P.J.; Urrutia, A.; Goicoechea, J.; Arregui, F.J. Nanomaterials for functional textiles and Fibers. Nanoscale Res. Lett. 2015, 10, 501. [Google Scholar] [CrossRef] [PubMed]
- Lin, J.; Chen, X.Y.; Chen, C.Y.; Hu, J.T.; Zhou, C.; Cai, X.F.; Wang, W.; Zheng, C.; Zhang, P.; Cheng, J.; et al. Durably antibacterial and bacterially antiadhesive cotton fabrics coated by cationic fluorinated polymers. ACS Appl. Mater. Interfaces 2018, 10, 6124–6136. [Google Scholar] [CrossRef] [PubMed]
- El-Rafie, M.H.; Shaheen, T.I.; Mohamed, A.A.; Hebeish, A. Bio-synthesis and applications of silver nanoparticles onto cotton fabrics. Carbohydr. Polym. 2012, 90, 915–920. [Google Scholar] [CrossRef]
- Liu, H.; Lv, M.; Deng, B.; Li, J.; Yu, M.; Huang, Q.; Fan, C. Laundering durable antibacterial cotton fabrics grafted with pomegranate-shaped polymer wrapped in silver nanoparticle aggregations. Sci. Rep. 2014, 4, 5920. [Google Scholar] [CrossRef] [PubMed]
- Deng, X.; Nikifolov, A.Y.; Coenye, T.; Cools, P.; Aziz, G.; Morent, R.; De Geyter, N.; Leys, C. Antimicrobial nano-silver non-woven polyethylene terephthalate fabric via an atmospheric pressure plasma deposition process. Sci. Rep. 2015, 5, 10138. [Google Scholar] [CrossRef] [PubMed]
- Han, J.W.; Ruiz-Garcia, L.; Qian, J.P.; Yang, X.T. Food packaging: A comprehensive review and future trends. Compr. Rev. Food Sci. Food Saf. 2018, 17, 860–877. [Google Scholar] [CrossRef]
- Bumbudsanpharoke, N.; Choi, J.; Ko, S. Applications of nanomaterials in food packaging. J. Nanosci. Nanotechnol. 2015, 15, 6357–6372. [Google Scholar] [CrossRef] [PubMed]
- Mousavi, F.P.; Pour, H.H.; Nasab, A.H.; Rajabalipour, A.A.; Barouni, M. Investigation into shelf life of fresh dates and pistachios in a package modified with nano-silver. Glob. J. Health Sci. 2015, 8, 134–144. [Google Scholar] [CrossRef] [PubMed]
- Tavakoli, H.; Rastegar, H.; Taherian, M.; Somadi, M.; Rostami, H. The effect of nano-silver packaging in increasing the shelf life of nuts: An in vitro model. Ital. J. Food Saf. 2017, 6, 6874. [Google Scholar] [CrossRef] [PubMed]
- Huang, Y.; Mei, L.; Chen, X.; Wang, Q. Recent developments in food packaging based on nanomaterials. Nanomaterials 2018, 8, 830. [Google Scholar] [CrossRef]
- Martınez-Abad, A.; Lagaron, J.M.; Ocio, M.J. Development and characterization of silver-based antimicrobial ethylene−vinyl alcohol copolymer (EVOH) films for food-packaging applications. J. Agric. Food Chem. 2012, 60, 5350–5359. [Google Scholar] [CrossRef]
- Russel, A.D. Challenge testing: Principles and practice. Int. J. Cosmet. Sci. 2003, 25, 147–153. [Google Scholar] [CrossRef] [PubMed]
- Chaloupka, K.; Malam, Y.; Seifalian, A.M. Nanosilver as a new generation of nanoproduct in biomedical applications. Trends Biotechnol. 2010, 28, 580–588. [Google Scholar] [CrossRef] [PubMed]
- Lopez-Carballo, G.; Higueras, L.; Gavara, R.; Hernandez-Muñoz, P. Silver ions release from antibacterial chitosan films containing in situ generated silver nanoparticles. J. Agric. Food Chem. 2013, 61, 260–267. [Google Scholar] [CrossRef]
- Huang, Y.; Chen, S.; Bing, X.; Gao, C.; Wang, T.; Yuan, B. Nanosilver migrated into food-simulating solutions from commercially available food fresh containers. Packag. Technol. Sci. 2011, 24, 291–297. [Google Scholar] [CrossRef]
- Echegoyen, Y.; Nerin, C. Nanoparticle release from nano-silver antimicrobial food containers. Food Chem. Technol. 2013, 62, 16–22. [Google Scholar] [CrossRef] [PubMed]
- You, C.; Li, Q.; Wang, X.; Wu, P.; Ho, J.K.; Jin, R.; Zhang, L.; Shao, H.; Han, C. Silver nanoparticle loaded collagen/chitosan scaffolds promote wound healing via regulating fibroblast migration and macrophage activation. Sci. Rep. 2017, 7, 10489. [Google Scholar] [CrossRef] [PubMed]
- Bhowmick, S.; Koul, V. Assessment of PVA/silver nanocomposite hydrogel patch as antimicrobial dressing scaffold: Synthesis, characterization and biological evaluation. Mater. Sci. Eng. C 2016, 59, 109–119. [Google Scholar] [CrossRef] [PubMed]
- Gonzalez-Sanchez, M.I.; Perni, S.; Tommasi, G.; Morris, N.J.; Hawkins, K.; Lopez-Cabarcos, E.; Prokopovich, P. Silver nanoparticle based antibacterial methacrylate hydrogels potential for bone graft applications. Mater. Sci. Eng. C 2015, 50, 332–340. [Google Scholar] [CrossRef]
- Oliveira, R.N.; Rouze, R.; Quilty, B.; Alves, G.G.; Soares, G.D.A.; Thire, R.M.S.; McGuinness, G.B. Mechanical properties and in vitro characterization of polyvinyl alcohol-nano-silver hydrogel wound dressings. Interf. Focus 2014, 4, 20130049. [Google Scholar] [CrossRef]
- De Matteis, V. Exposure to inorganic nanoparticles: Routes of entry, immune response, biodistribution and in vitro/in vivo toxicity evaluation. Toxics 2017, 5, 29. [Google Scholar] [CrossRef]
- Zhang, S.; Gao, H.; Bao, G. Physical process of nanoparticle cellular endocytosis. ACS Nano 2015, 9, 8655–8671. [Google Scholar] [CrossRef] [PubMed]
- Akter, M.; Sikder, M.T.; Rahman, M.; Ullah, A.K.; Hossain, K.F.; Banik, S.; Hosokawa, T.; Saito, T.; Kurasaki, M. A systematic review on silver nanoparticles-induced cytotoxicity: Physicochemical properties and perspectives. J. Adv. Res. 2018, 9, 1–16. [Google Scholar] [CrossRef] [PubMed]
- Fu, P.P.; Xia, Q.; Huang, H.M.; Ray, P.C.; Yu, H. Mechanisms of nanotoxicity: Generation of reactive oxygen species. J. Food Drug. Anal. 2014, 22, 64–75. [Google Scholar] [CrossRef] [PubMed]
- Grzelak, A.; Wojewodzka, M.; Meczynska-Wielgosz, S.; Zuberek, M.; Wojciechowska, D.; Kruszewski, M. Crucial role of chelatable iron in silver nanoparticles induced DNA damage and cytotoxicity. Redox Biol. 2018, 15, 435–440. [Google Scholar] [CrossRef] [PubMed]
- AshaRani, P.V.; Hande, M.P.; Valiyaveettil, S. Anti-proliferative activity of silver nanoparticles. BMC Cell Biol. 2009, 10, 65. [Google Scholar] [CrossRef] [PubMed]
- Zhang, X.F.; Shen, W.; Gurunathan, S. Silver nanoparticle-mediated cellular responses in various cell lines: An in vitro model. Int. J. Mol. Sci. 2016, 17, 1603. [Google Scholar] [CrossRef] [PubMed]
- Riaz Ahmed, K.B.; Nagy, A.M.; Brown, R.P.; Zhang, Q.; Malghan, S.G.; Goering, P.L. Silver nanoparticles: Significance of physicochemical properties and assay interference on the interpretation of in vitro cytotoxicity studies. Toxicol. In Vitro 2017, 38, 179–192. [Google Scholar] [CrossRef]
- Han, J.W.; Gurunathan, S.; Jeong, J.K.; Choi, Y.J.; Kwon, D.N.; Park, J.K.; Kim, J.H. Oxidative stress mediated cytotoxicity of biologically synthesized silver nanoparticles in human lung epithelial adenocarcinoma cell line. Nanoscle Res. Lett. 2014, 9, 459. [Google Scholar] [CrossRef]
- Xue, Y.; Zhang, T.; Zhang, B.; Gong, F.; Huang, Y.; Tang, M. Cytotoxicity and apoptosis induced by silver nanoparticles in human liver HepG2 cells in different dispersion media. J. Appl. Toxicol. 2015, 36, 352–360. [Google Scholar] [CrossRef]
- Hsiao, I.L.; Hsieh, Y.K.; Wang, C.F.; Chen, I.C.; Huang, Y.J. Trojan-horse mechanism in the cellular uptake of silver nanoparticles verified by direct intra- and extracellular silver speciation analysis. Environ. Sci. Technol. 2015, 49, 3813–3821. [Google Scholar] [CrossRef]
- Pourzahedi, L.; Vance, M.; Eckelman, M.J. Life cycle assessment and release studies for nanosilver-enabled consumer products: Investigating hotspots and patterns of contribution. Environ. Sci. Technol. 2017, 51, 7148–7158. [Google Scholar] [CrossRef]
- Theodorou, I.G.; Ryan, M.P.; Tetley, T.D.; Porter, A.E. Inhalation of silver nanomaterials—Seeing the risk. Int. J. Mol. Sci. 2014, 15, 23936–23974. [Google Scholar] [CrossRef]
- Fordbjerg, R.; Irwing, E.S.; Hayashi, Y.; Sutherland, D.S.; Thorsen, K.; Autrup, S.; Beer, C. Global gene expression profiling of human lung epithelial cells after exposure to nanosilver. Toxicol. Sci. 2012, 130, 145–157. [Google Scholar] [CrossRef] [PubMed]
- Gurunathan, S.; Kang, M.H.; Kim, J.H. Combination effect of silver nanoparticles and histone deacetylases inhibitor in human alveolar basal epithelial cells. Molecules 2018, 23, 2046. [Google Scholar] [CrossRef]
- Nymark, P.; Catalan, J.; Suhonen, S.; Jarventaus, H.; Bilkeda, R.; Clausen, P.A.; Jensen, K.A.; Vippola, M.; Savolainen, K.; Norppa, H. Genotoxicity of polyvinylpyrrolidone-coated silver nanoparticles in BEAS 2B cells. Toxicology 2013, 313, 38–48. [Google Scholar] [CrossRef] [PubMed]
- Gliga, A.R.; Skoglund, S.; Wallinder, I.O.; Fadee, B.; Karlsson, H.L. Size-dependent cytotoxicity of silver nanoparticles in human lung cells: The role of cellular uptake, agglomeration and Ag release. Part. Fibre Toxicol. 2014, 11, 11. [Google Scholar] [CrossRef] [PubMed]
- Kim, H.R.; Kim, M.J.; Lee, S.Y.; Oh, S.M.; Chung, K.H. Genotoxic effects of silver nanoparticles stimulated by oxidative stress in human normal bronchial epithelial (BEAS-2B) cells. Mutat Res. 2011, 726, 129–135. [Google Scholar] [CrossRef]
- Sapkota, K.; Narayanan, K.B.; Han, S.S. Environmentally sustainable synthesis of catalytically active silver nanoparticles and their cytotoxic effect on human keratinocytes. J. Clust. Sci. 2017, 28, 1605–1616. [Google Scholar] [CrossRef]
- Avalos, A.S.; Haza, A.I.; Morales, P. Manufactured silver nanoparticles of different sizes induced DNA strand breaks and oxidative DNA damage in hepatoma and leukaemia cells and in dermal and pulmonary fibroblasts. Folia Biol. 2015, 61, 33–42. [Google Scholar]
- Avalos, A.S.; Haza, A.I.; Mateo, D.; Morales, P. Interactions of manufactured silver nanoparticles of different sizes with normal human dermal fibroblasts. Int. Wound J. 2016, 13, 101–109. [Google Scholar] [CrossRef]
- Huo, L.; Chen, R.; Zhao, L.; Shi, X.; Bai, R.; Long, D.; Chen, F.; Zhao, Y.; Chang, Y.Z.; Chen, C. Silver nanoparticles activate endoplasmic reticulum stress signaling pathway in cell and mouse models: The role in toxicity evaluation. Biomaterials 2015, 61, 307–315. [Google Scholar] [CrossRef] [PubMed]
- Matuszak, J.; Baumgartner, J.; Zaloga, J.; Juenet, M.; da Silva, A.E.; Franke, D.; Almer, G.; Texier, I.; Faivre, D.; Metselaar, J.M.; et al. Nanoparticles for intravascular applications: Physicochemical characterization and cytotoxicity testing. Nanomedicine 2016, 11, 597–616. [Google Scholar] [CrossRef] [PubMed]
- Gromnicova, R.; Kaya, M.; Romero, I.A.; Williams, P.; Satchell, S.; Sharrack, B.; Male, D. Transport of gold nanoparticles by vascular endothelium from different human tissues. PLoS ONE 2016, 11, e0161610. [Google Scholar] [CrossRef] [PubMed]
- Cao, Y.; Gong, Y.; Liu, L.; Zhou, Y.; Fang, X.; Zhang, C.; Li, Y.; Li, J. The use of human umbilical vein endothelial cells (HUVECs) as an in vitro model to assess the toxicity of nanoparticles to endothelium: A review. J. Appl. Toxicol. 2017, 37, 1359–1369. [Google Scholar] [CrossRef] [PubMed]
- Guo, H.; Zhang, Z.; Boudreau, M.; Meng, J.; Ying, J.J.; Liu, J.; Xu, H. Intravenous administration of silver nanoparticles causes organ toxicity through intracellular ROS-related loss of inter-endothelial junction. Part Fibre Toxicol. 2016, 13, 21. [Google Scholar] [CrossRef] [PubMed]
- Zuberek, M.; Wojciechowska, D.; Krzyzanowski, D.; Meczynska-Wielgosz, S.; Kruszewski, M.; Grzelak, A. Glucose availability determines silver nanoparticles toxicity in HepG2. J. Nanobiotechnol. 2015, 13, 72. [Google Scholar] [CrossRef] [PubMed]
- Singh, A.; Dar, M.Y.; Joeshi, B.; Sharma, B.; Shrisvatava, S.; Sukla, S. Phytofabrication of silver nanoparticles: Novel drug to overcome hepatocellular ailments. Toxicol. Rep. 2018, 5, 333–342. [Google Scholar] [CrossRef] [PubMed]
- Chen, L.Q.; Fang, L.; Ling, J.; Ding, C.Z.; Kang, B.; Huang, C.Z. Nanotoxicity of silver nanoparticles to red blood cells: Size-dependent adsorption, uptake and hemolytic activity. Chem. Res. Toxicol. 2015, 28, 501–509. [Google Scholar] [CrossRef] [PubMed]
- Ferdous, Z.; Beegam, S.; Tariq, S.; Ali, B.H.; Nemmar, A. The in vitro effect of polyvinylpyrrolidone and citrate coated silver nanoparticles on erythrocytic oxidative damage and eryptosis. Cell Physiol. Biochem. 2018, 49, 1577–1588. [Google Scholar] [CrossRef] [PubMed]
- Carlson, C.; Hussain, S.M.; Schrand, A.M.; Braydich-Stolle, L.K.; Hess, K.L.; Jones, R.L.; Schlager, J.J. Unique cellular interaction of solver nanoparticles: Size-dependent generation of reactive oxygen species. J. Phys. Chem. B 2008, 112, 13608–13619. [Google Scholar] [CrossRef] [PubMed]
- Yang, E.J.; Kim, S.; Kim, J.S.; Choi, I.H. Inflammasome formation and IL-1β release by human blood monocytes in response to silver nanoparticles. Biomaterials 2012, 33, 6858–6867. [Google Scholar] [CrossRef] [PubMed]
- Martinez-Gutierrez, F.; Thi, E.P.; Silverman, J.M.; De Oliveira, C.C.; Svensson, S.L.; Vanden Hoek, A.; Sanchez, E.M.; Reiner, N.E.; Gaynor, E.C.; Pryzdial, E.L.; et al. Antibacterial activity, inflammatory response, coagulation and cytotoxicity effects of silver nanoparticles. Nanomedicine 2012, 8, 328–336. [Google Scholar] [CrossRef] [PubMed]
- Feng, X.; Chen, A.; Zhang, Y.; Wang, J.; Shao, L.; Wei, L. Central nervous system toxicity of metallic nanoparticles. Int. J. Nanomed. 2015, 10, 4321–4340. [Google Scholar] [CrossRef]
- Cramer, S.; Tacke, S.; Bornhors, J.; Klingauf, J.; Schwerdtl, T.; Galla, H.J. The influence of silver nanoparticles on the blood-brain and the blood-cerebrospinal fluid barrier in vitro. J. Nanomed. Nanotechnol. 2014, 5, 225. [Google Scholar] [CrossRef]
- Liu, F.; Mahmood, M.; Xu, Y.; Watanabe, F.; Biris, A.S.; Hansen, D.K.; Inselman, A.; Casciano, D.; Patterson, T.A.; Paule, M.G.; et al. Effects of silver nanoparticles on human and rat embryonic neural stem cells. Front. Neurosci. 2015, 9, 115. [Google Scholar] [CrossRef] [PubMed]
- Yin, N.; Hu, B.; Yang, R.; Liang, S.; Liang, S.X.; Faiola, F. Assessment of the developmental neurotoxicity of silver nanoparticles and silver ions with mouse embryonic stem cells in vitro. JOIN 2018, 3, 133–145. [Google Scholar] [CrossRef]
- Ma, W.; Jing, L.; Valladares, A.; Mehta, S.L.; Wang, Z.; Li, P.A.; Bang, J.J. Stress, caspase-3 activation and cell death: Amelioration by sodium selenite. Int. J. Biol. Sci. 2015, 11, 86–867. [Google Scholar] [CrossRef]
- McIlwain, D.R.; Berger, T.; Mak, T.W. Caspase functions in cell death and disease. Cold Spring Harb. Perspect. Biol. 2013, 5, a008656. [Google Scholar] [CrossRef]
- Iturri, J.; Toca-Herrera, J.L. Characterization of cell scaffolds by atomic force microscopy. Polymers 2017, 9, 383. [Google Scholar] [CrossRef]
- Variola, F. Atomic force microscopy in biomaterials surface science. Phys. Chem. Chem. Phys. 2015, 17, 2950–2959. [Google Scholar] [CrossRef]
- Subbiah, R.; Jeon, S.B.; Park, K.; Ahn, S.J.; Yun, K. Investigation of cellular responses upon interaction with silver nanoparticles. Int. J. Nanomed. 2015, 10, 191–201. [Google Scholar] [CrossRef]
- Franco, R.; Cidlowski, J.A. Apoptosis and glutathione: Beyond an antioxidant. Cell Death Differ. 2009, 16, 1303–1314. [Google Scholar] [CrossRef] [PubMed]
- Turner, P.V.; Brabb, T.; Pekow, C.; Vasbinde, M.A. Administration of substances to laboratory animals: Routes of administration and factors to consider. J. Am. Assoc. Lab. Anim. Sci. 2011, 50, 600–613. [Google Scholar] [PubMed]
- Recordati, C.; De Maglie, M.; Bianchessi, S.; Argentiere, S.; Cella, C.; Mattiello, S.; Cubadda, F.; Aureli, F.; D’Amato, M.; Raggi, A.; et al. Tissue distribution and acute toxicity of silver after single intravenous administration in mice: Nano-specific and size-dependent effects. Part. Fibre Toxicol. 2016, 13, 12. [Google Scholar] [CrossRef] [PubMed]
- Yang, L.; Kuang, H.; Zhang, W.; Aguilar, Z.P.; Wei, H.; Xu, H. Comparisons of the biodistribution and toxicological examinations after repeated intravenous administration of silver and gold nanoparticles in mice. Sci. Rep. 2017, 7, 3303. [Google Scholar] [CrossRef] [PubMed]
- Wen, H.; Dan, M.; Yang, Y.; Lyu, J.; Shao, A.; Cheng, X.; Chen, L.; Xu, L. Acute toxicity and genotoxicity of silver nanoparticle in rats. PLoS ONE 2017, 12, e0185554. [Google Scholar] [CrossRef] [PubMed]
- Wen, H.; Yang, X.; Hu, L.; Sun, C.; Zhou, Q.; Jiang, G. Brain-targeted distribution and high retention of silver by chronic intranasal instillation of silver nanoparticles and ions in Sprague–Dawley rats. J. Appl. Toxicol. 2015, 36, 445–453. [Google Scholar] [CrossRef] [PubMed]
- Gaiser, B.K.; Hirn, S.; Kermanizadeh, A.; Kanase, N.; Fytianos, K.; Wenk, A.; Harbel, N.; Brunelli, A.; Kreyling, W.G.; Stove, V. Effects of silver nanoparticles on the liver and hepatocytes in vitro. Toxicol. Sci. 2013, 131, 537–547. [Google Scholar] [CrossRef]
- Dziendzikowska, K.; Gromadzka-Ostrowska, J.; Lankoff, A.; Oczkowski, M.; Krawczynska, A.; Chwastowska, J.; Sadowska-Bratek, M.; Chajduk, E.; Wojewodzka, M.; Kruszewski, M. Time-dependent biodistribution and excretion of silver nanoparticles in male Wistar rats. J. Appl. Toxicol. 2012, 32, 920–928. [Google Scholar] [CrossRef]
- Lee, T.Y.; Liu, M.S.; Huang, L.J.; Lue, S.I.; Lin, L.C.; Kwan, A.L.; Yang, R.C. Bioenergetic failure correlates with autophagy and apoptosis in rat liver following silver nanoparticle intraperitoneally administration. Part. Fibre Toxicol. 2013, 10, 40. [Google Scholar] [CrossRef]
- Sadauskas, E.; Wallin, H.; Stoltenberg, M.; Vogel, U.; Doering, P.; Larsen, A.; Danscher, G. Kupffer cells are central in the removal of nanoparticles from the organism. Part. Fibre Toxicol. 2007, 4, 10. [Google Scholar] [CrossRef] [PubMed]
- Sarhan, O.M.; Hussein, R.M. Effects of intraperitoneally injected silver nanoparticles on histological structures and blood parameters in the albino rat. Int. J. Nanomed. 2014, 9, 1505–1517. [Google Scholar] [CrossRef]
- Qin, G.; Tang, S.; Li, S.; Lu, H.; Wang, Y.; Zhao, P.; Li, B.; Zhang, J.; Peng, L. Toxicological evaluation of silver nanoparticles and silver nitrate in rats following 28 days of repeated oral exposure. Environ. Toxicol. 2017, 32, 609–618. [Google Scholar] [CrossRef] [PubMed]
- Zhang, X.F.; Park, J.H.; Choi, Y.J.; Kang, M.H.; Gurunathan, S.; Kim, J.H. Silver nanoparticles cause complications in pregnant mice. Int. J. Nanomed. 2015, 10, 7057–7071. [Google Scholar] [CrossRef]
- Fennell, T.R.; Mortensen, N.P.; Black, S.R.; Snyder, R.W.; Levine, K.E.; Poitras, E.; Harrington, J.M.; Wingard, C.J.; Holland, N.A.; Patmasiri, W. Disposition of intravenously or orally administered silver nanoparticles in pregnant rats and the effect on the biochemical profile in urine. J. Appl. Toxicol. 2017, 37, 530–544. [Google Scholar] [CrossRef] [PubMed]
- Hadrup, N.; Loeschner, K.; Mortensen, A.; Sharma, A.K.; Qvortrup, K.; Larsen, E.H.; Lam, H.R. The similar neurotoxic effects of nanoparticulate and ionic silver in vivo and in vitro. Neurotoxicol. 2012, 33, 416–423. [Google Scholar] [CrossRef] [PubMed]
- Xu, L.; Dan, M.; Shao, A.; Cheng, X.; Zhang, C.; Yokel, R.A.; Takemura, T.; Hanagata, N.; Niwa, M.; Wanatabe, D. Silver nanoparticles induce tight junction disruption and astrocyte neurotoxicity in a rat blood–brain barrier primary triple coculture model. Int. J. Nanomed. 2015, 10, 6105–6119. [Google Scholar] [CrossRef]
- Xu, L.; Shao, A.; Zhao, Y.; Wang, Z.; Zhang, C.; Sun, Y.; Deng, J.; Cho, L.L. Neurotoxicity of silver nanoparticles in rat brain after intragastric exposure. J. Nanosci. Nanotechnol. 2014, 9, 1–14. [Google Scholar] [CrossRef]
- Dabrowska-Bouta, B.; Sulkowski, G.; Struzynski, W.; Struzynska, L. Prolonged exposure to silver nanoparticles results in oxidative stress in cerebral myelin. Neurotox. Res. 2018, 34, 1–10. [Google Scholar] [CrossRef]
- Bergin, I.L.; Wilding, L.A.; Morishita, M.; Walacavage, K.; Ault, A.P.; Axson, J.L.; Stark, D.I.; Hashway, S.A.; Capracotta, S.S.; Leroueil, P.R.; et al. Effects of particle size and coating on toxicologic parameters, fecal elimination kinetics and tissue distribution of acutely ingested silver nanoparticles in a mouse model. Nanotoxicology 2016, 10, 352–360. [Google Scholar] [CrossRef]
- Boudreau, M.D.; Imam, M.S.; Paredes, A.M.; Bryant, M.S.; Cunningham, C.K.; Felton, R.P.; Jones, M.Y.; Davis, K.J.; Olson, G.R. Differential effects of silver nanoparticles and silver ions on tissue accumulation, distribution, and toxicity in the Sprague Dawley rat following daily oral gavage administration for 13 weeks. Toxicol. Sci. 2016, 150, 131–160. [Google Scholar] [CrossRef] [PubMed]
- Park, K. Toxicokinetic differences and toxicities of silver nanoparticles and silver ions in rats after single oral administration. J. Toxicol. Environ. Health Part A 2013, 76, 1246–1260. [Google Scholar] [CrossRef] [PubMed]
- Van der Zande, M.; Vandebriel, R.J.; Doren, E.V.; Kramer, E.; Rivera, Z.H.; Serrano-Rojero, C.S.; Gremmer, E.R.; Mast, J.; Peters, R.J.; Hollman, P.C.; et al. Distribution, elimination, and toxicity of silver nanoparticles and silver ions in rats after 28-day oral exposure. ACS Nano 2012, 6, 7427–7442. [Google Scholar] [CrossRef] [PubMed]
- Li, N.; Georas, S.; Alexis, N.; Fritz, P.; Xia, T.; Williams, M.A.; Horner, E.; Nel, A. A work group report on ultrafine particles (American Academy of Allergy, Asthma & Immunology): Why ambient ultrafine and engineered nanoparticles should receive special attention for possible adverse health outcomes in human subjects. J. Allergy Clin. Immunol. 2016, 138, 386–396. [Google Scholar] [CrossRef] [PubMed]
- Morimoto, Y.; Izumi, H.; Yoshiura, Y.; Fujishima, K.; Yatera, K.; Yamamoto, K. Usefulness of intratracheal instillation studies for estimating nanoparticle-induced pulmonary toxicity. Int. J. Mol. Sci. 2016, 17, 165. [Google Scholar] [CrossRef] [PubMed]
- Anderson, D.S.; Silva, R.M.; Lee, D.; Edwards, P.C.; Sharmah, A.; Guo, T.; Pinkerton, K.E.; Van Winkle, L.S. Persistence of silver nanoparticles in the rat lung: Influence of dose, size, and chemical composition. Nanotoxicology 2015, 9, 591–602. [Google Scholar] [CrossRef] [PubMed]
- Seiffert, J.; Hussain, F.; Wiegman, C.; Li, F.; Bey, L.; Baker, W.; Porter, A.; Ryan, M.P.; Chang, Y.; Gow, A.; et al. Pulmonary toxicity of instilled silver nanoparticles: Influence of size, coating and rat strain. PLoS ONE 2015, 10, e0119726. [Google Scholar] [CrossRef] [PubMed]
- Roda, E.; Barni, S.; Milzani, A.; Dalle-Donne, I.; Colombo, G.; Coccini, T. Single silver nanoparticle instillation induced early and persisting moderate cortical damage in rat kidneys. Int. J. Mol. Sci. 2017, 18, 2115. [Google Scholar] [CrossRef] [PubMed]
- Wiemann, M.; Vennemann, A.; Blaske, F.; Sperling, M.; Karst, U. Silver nanoparticles in the lung: Toxic effects and focal accumulation of silver in remote organs. Nanomaterials 2017, 7, 441. [Google Scholar] [CrossRef] [PubMed]
- Jena, P.; Mohanty, S.; Mallick, R.; Jacob, B.; Sonawane, A. Toxicity and antibacterial assessment of chitosan coated silver nanoparticles on human pathogens and macrophage cells. Int. J. Nanomed. 2012, 7, 1805–1818. [Google Scholar] [CrossRef]
- Sanchez, G.R.; Catilla, C.L.; Gomez, N.B.; Garcia, A.; Marcos, R.; Carmona, E.R. Leaf extract from the endemic plant Peumus boldus as an effective bioproduct for the green synthesis of silver nanoparticles. Mater. Lett. 2016, 183, 255–260. [Google Scholar] [CrossRef]

| Bacterium | AgNP Content (ppm) in Fabrics | Percentage of Bacterial Reduction | Number of Washing | ||
|---|---|---|---|---|---|
| 0 | 10 | 20 | 30 | ||
| E. coli | 100 | 99.99 | 99.99 | 99.46 | 99.20 |
| E. coli | 200 | 99.99 | 99.99 | 99.99 | 99.55 |
| S. aureus | 100 | 99.99 | 99.86 | 99.27 | 86.92 |
| S. aureus | 200 | 99.99 | 99.57 | 99.27 | 91.03 |
| Synthetic Route and Size | AgNPs Dosage and Exposure Time | Cell Type | Cytotoxic Effect | Ref. |
|---|---|---|---|---|
| Green & chemical reduction; 15 nm | 10, 20, 30, 40 and 50 µg/mL for 24 h | A549 | ROS creation, MMP reduction, LDH leakage, phagocytosis | [193] |
| Green synthesis; 11 nm | AgNP (1 µM) + MS-275 (1 µM) for 24 h | A549 | Apoptosis due to ROS creation, LDH leakage, mitochondria dysfunction, DNA fragmentation | [199] |
| Chemical reduction; 15.9 ± 7.6 nm | 12.1 µg/mL for 24 and 48 h | A549 | Exposure of AgNPs for 24 h altered the regulation of more than 1000 genes; ROS generation | [198] |
| Chemical reduction; 19.5 nm | 1.25, 2.5, 5, 10, 20 and 40 µg/mL for 24 h | A549, HS-5; NIH3T3 | AgNPs treatment increased surface roughness and stiffness of the cells. | [226] |
| Commercial particles; CT-AgNPs: 10, 40, 75 nm; PVP-AgNPs: 10 nm | 5, 10, 20 and 50 µg/mL for 24 h | BEAS-2B | Size-dependent toxicity. AgNPs with 10 nm were more toxic, leading to DNA damage without ROS generation | [201] |
| Commercial particles; CT-AgNPs: 10, 30 and 60 nm | 10 and 40 µg/mL for 24 h and 48 h | HaCaT | Dose-dependent ROS generation | [49] |
| Green synthesis; 20 nm | 10, 20, 40, 60, 80 and 100 µg/mL for 24 h | CRL-2310 | Dose-dependent toxicity. Cell viability was 98.76% at 10 µg/mL, but reduced to 74.5% at 100 µg/mL | [203] |
| Commercial particles; Pristine AgNPs: 42 nm; PEI/PVP coated-AgNPs: 4.7 nm | AgNPs: 0.1, 0.5, 1.6 and 6.7 µg/mL. Coated AgNPs: 0.1, 0.5, 0.8, 1.6 µg/mL | HPF and NDHF | DNA strand breaks in a dose- and time-dependent manner. Smaller coated-AgNPs were more genotoxic than larger pristine AgNPs | [204] |
| Chemical reduction; 65 nm | 0.5, 1, 1.5 and 2 µg/mL | HUVEC | Dose-dependent toxicity. ROS creation and cell dysfunction via IKK/NF-κB pathways | [54] |
| Commercial particles; <100 nm | 5, 10, 15, 25, 35, 40 and 50 µg/mL for 24 h | HBEC5i; HUVEC; EA.hy926 | Cell viability and membrane damage were dose-dependent. | [59] |
| Commercial particles; 15 nm | 40, 80 and 160 µg/mL for 24 h and 48 h | HepG2 | Dose-dependent cytotoxicity. ROS creation, MPP reduction & apoptosis | [194] |
| Green synthesis; 10–50 nm | 1, 5, 10, 20, 40 and 80 µg/mL for 24 h | HepG2 | Dose-dependent cytotoxicity; IC50 = 20 µg/mL | [212] |
| Commercial particles; 60 nm | 10, 20 and 40 µg/mL for 24 h | HEK293T | Decreased cell viability, increased DNA damage by exposing to AgNPs with increasing concentration | [55] |
| Chemical reduction; AgNPs: 30 and 100 nm AgNWs: length (1–2 µm) | 100, 200, 300, 400 and 500 µg/mL for 2 h | Human erythrocyte | Size- and dose- dependent hemolysis | [50] |
| Commercial particles; 5, 28 and 100 nm | 0.15, 3, 6, 9, 1.15, 1.25, 2.5 and 6.25 µg/mL for 6 h | PBMC | Dose-dependent cytotoxicity. AgNPs induced inflammasomes to produce IL-1β. | [216] |
| Green synthesis; 24.4 nm | 2, 5, 6.25, 10, 12.5, 50 µg/mL for 24 h | THP-1 | Cell death more than 42% at 12.5 µg/mL AgNPs. Induced cytokines IL-6 and TNF-α | [217] |
| Commercial particles; 10, 20, 50 and 100 nm | 1, 2.5, 5, 10, 15 and 25 µg/mL for 24 h | THP-1 | AgNPs (10 nm) and AgNPs (20 nm) induced DNA damage | [60] |
| Chemical reduction; 23 nm | 1, 5, 10, 20 µg/mL for 24 h | NSC | Reduction in mitochondrial metabolism; increased LDH leakage and ROS level | [220] |
| Coating Type & Size of AgNPs | Model | Dosage & Exposure Time | Entry Route | Cytotoxic Effect | Ref. |
|---|---|---|---|---|---|
| CT and PVP; 10, 40 &100 nm | CD-1 Mice | 10 mg/kg bw;24 h | i.v. | Biodistributed in spleen and liver followed by lung, kidney and brain. AgNPs (10 nm) are the most toxic nanoparticles | [229] |
| Carboxyl; 3 nm | KM Mice | 11.3–13.3 mg/kg bw; 4 weeks | i.v. | Biodistributed mainly in spleen and liver, followed by kidney, lung, heart and testis | [230] |
| CT; 6.3 nm | SD rats | 5 mg/kg bw; 24 h | i.v. | Biodistributed in the organs with decreasing Ag concentration, i.e., lung > spleen > liver > kidney > thymus > heart | [231] |
| PVP; 26.2 nm | SD rats | 0.1 and 1 mg/kg bw per day for 4 and 12 weeks | Intranasal instillation | Dose- and time-dependent accumulation of both AgNPs and silver ion (AgNO3) in liver, lung and brain | [232] |
| 2 and 20 nm | Wistar rats | 5 mg/kg bw; 1, 7and 28 days | i.v. | Time- and size-dependent accumulation of AgNPs in the liver, spleen, kidney and brain | [234] |
| PVP; 10–30 nm | SD rats | 500 mg/kg bw; 1, 4, 7, 10 and 30 days | i.p. | AgNPs located mainly in the liver. A significant increase in caspase-3 in the liver of treated rats from day 1 to day 30 | [235] |
| CT; 3–10 nm | SD rats | 1mg/kg bw. and 10 mg/kg bw for 14 days | Intragastric | Neuron shrinkage, cytoplasmic or foot swelling of astrocytes and inflammation | [229] |
| CT; 10 nm | Wistar rats | 0.2 mg/kg bw per day for 14 days | Gastro-intestinal | Enhanced lipid peroxidation and decreased concentrations of protein and non-protein –SH groups in myelin | [243] |
| CT, PVP; 20 and 110 nm | Black 6 mice | 0.1, 1, 100 mg/kg bw per day for 3 days | Oral gavage | No toxicity and no significant tissue accumulation | [245] |
| CT; 10, 75 & 110 nm | SD rats | 9, 18, 36 mg/kg bw for 13 weeks | Oral gavage | AgNPs predominantly deposited within cells of major organs | [246] |
| PVP; 28–43 nm | SD rats | 0.5 and 1 mg/kg bw daily for 28 days | Oral admi-nistration | Biodistributed in liver, kidney, spleen and blood plasma. | [238] |
| CT, PVP; 20 and 110 nm | SD rats | 0.5 and 1 mg/kg bw for 1, 7 and 21 days | i.t. instillation | CT-AgNPs persisted in the lung to 21 days with retention >90%, while PVP-AgNP had lower retention of less than 30%. CT-AgNPs triggered lung macrophages for clearance of AgNPs | [251] |
© 2019 by the authors. Licensee MDPI, Basel, Switzerland. This article is an open access article distributed under the terms and conditions of the Creative Commons Attribution (CC BY) license (http://creativecommons.org/licenses/by/4.0/).
Share and Cite
Liao, C.; Li, Y.; Tjong, S.C. Bactericidal and Cytotoxic Properties of Silver Nanoparticles. Int. J. Mol. Sci. 2019, 20, 449. https://doi.org/10.3390/ijms20020449
Liao C, Li Y, Tjong SC. Bactericidal and Cytotoxic Properties of Silver Nanoparticles. International Journal of Molecular Sciences. 2019; 20(2):449. https://doi.org/10.3390/ijms20020449
Chicago/Turabian StyleLiao, Chengzhu, Yuchao Li, and Sie Chin Tjong. 2019. "Bactericidal and Cytotoxic Properties of Silver Nanoparticles" International Journal of Molecular Sciences 20, no. 2: 449. https://doi.org/10.3390/ijms20020449
APA StyleLiao, C., Li, Y., & Tjong, S. C. (2019). Bactericidal and Cytotoxic Properties of Silver Nanoparticles. International Journal of Molecular Sciences, 20(2), 449. https://doi.org/10.3390/ijms20020449

